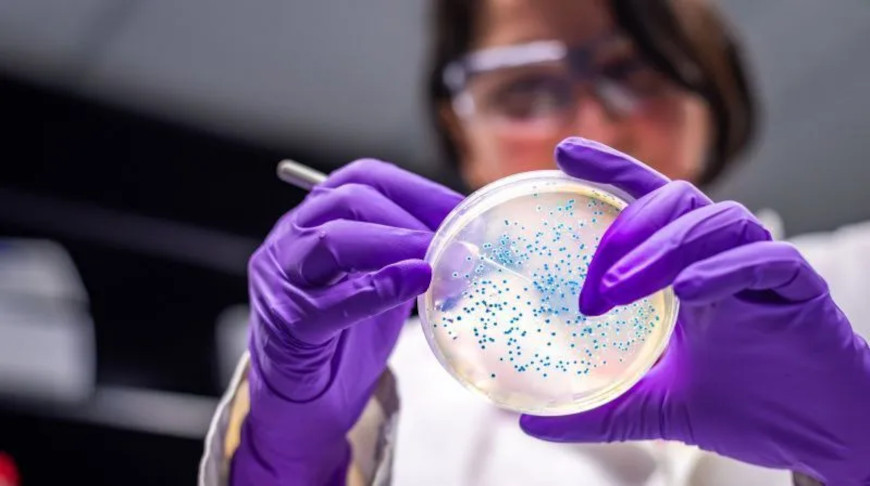
Photo: Manjurul / iStock

Photo: Manjurul / iStock
MOSCOW, 23 March (BelTA - TV BRICS) - Researchers at the Kola
Science Centre of the Russian Academy of Sciences have identified
bacterial strains in the Murmansk Region capable of cleaning soil from
petroleum products and heavy metals in the Arctic. This was reported on
the website of the Russian Ministry of Science and Higher Education.
The study was conducted on Mount Kaskama in the north-west of the Murmansk Region, where a polluted zone has formed. From the collected samples, scientists isolated ten of the most active microbial strains. All of them are able to grow at temperatures of around +5 °C, tolerate high concentrations of heavy metal ions, and use components of diesel fuel and crude oil as a carbon source.
Of particular interest to researchers are bacteria of the Pseudomonas genus, which oxidise ferrous iron, and Paenibacillus, capable of reducing ferric iron while simultaneously oxidising hydrocarbons in an oxygen-free environment. This makes it possible to tackle contamination at different depths of the soil layer.
Pollution from petroleum products and heavy metals remains a major challenge for the Arctic. Due to the harsh climate, permafrost and logistical constraints, conventional remediation methods such as soil removal, incineration or chemical washing are often impractical.
Low temperatures slow down the evaporation of toxic hydrocarbons and the natural self-purification of soil. Scientists believe that the identified strains, which efficiently oxidise hydrocarbons, could be used for bioremediation of northern soils. This opens up prospects for cleaning the Arctic using indigenous (autochthonous) microorganisms rather than those introduced from outside.
The research was carried out by scientists from the Institute of North Industrial Ecology Problems of the Kola Science Centre of the Russian Academy of Sciences, in collaboration with colleagues from Peoples' Friendship University of Russia and the S. N. Vinogradsky Institute of Microbiology of the Federal Research Centre “Fundamentals of Biotechnology” of the Russian Academy of Sciences.
The study was conducted on Mount Kaskama in the north-west of the Murmansk Region, where a polluted zone has formed. From the collected samples, scientists isolated ten of the most active microbial strains. All of them are able to grow at temperatures of around +5 °C, tolerate high concentrations of heavy metal ions, and use components of diesel fuel and crude oil as a carbon source.
Of particular interest to researchers are bacteria of the Pseudomonas genus, which oxidise ferrous iron, and Paenibacillus, capable of reducing ferric iron while simultaneously oxidising hydrocarbons in an oxygen-free environment. This makes it possible to tackle contamination at different depths of the soil layer.
Pollution from petroleum products and heavy metals remains a major challenge for the Arctic. Due to the harsh climate, permafrost and logistical constraints, conventional remediation methods such as soil removal, incineration or chemical washing are often impractical.
Low temperatures slow down the evaporation of toxic hydrocarbons and the natural self-purification of soil. Scientists believe that the identified strains, which efficiently oxidise hydrocarbons, could be used for bioremediation of northern soils. This opens up prospects for cleaning the Arctic using indigenous (autochthonous) microorganisms rather than those introduced from outside.
The research was carried out by scientists from the Institute of North Industrial Ecology Problems of the Kola Science Centre of the Russian Academy of Sciences, in collaboration with colleagues from Peoples' Friendship University of Russia and the S. N. Vinogradsky Institute of Microbiology of the Federal Research Centre “Fundamentals of Biotechnology” of the Russian Academy of Sciences.













